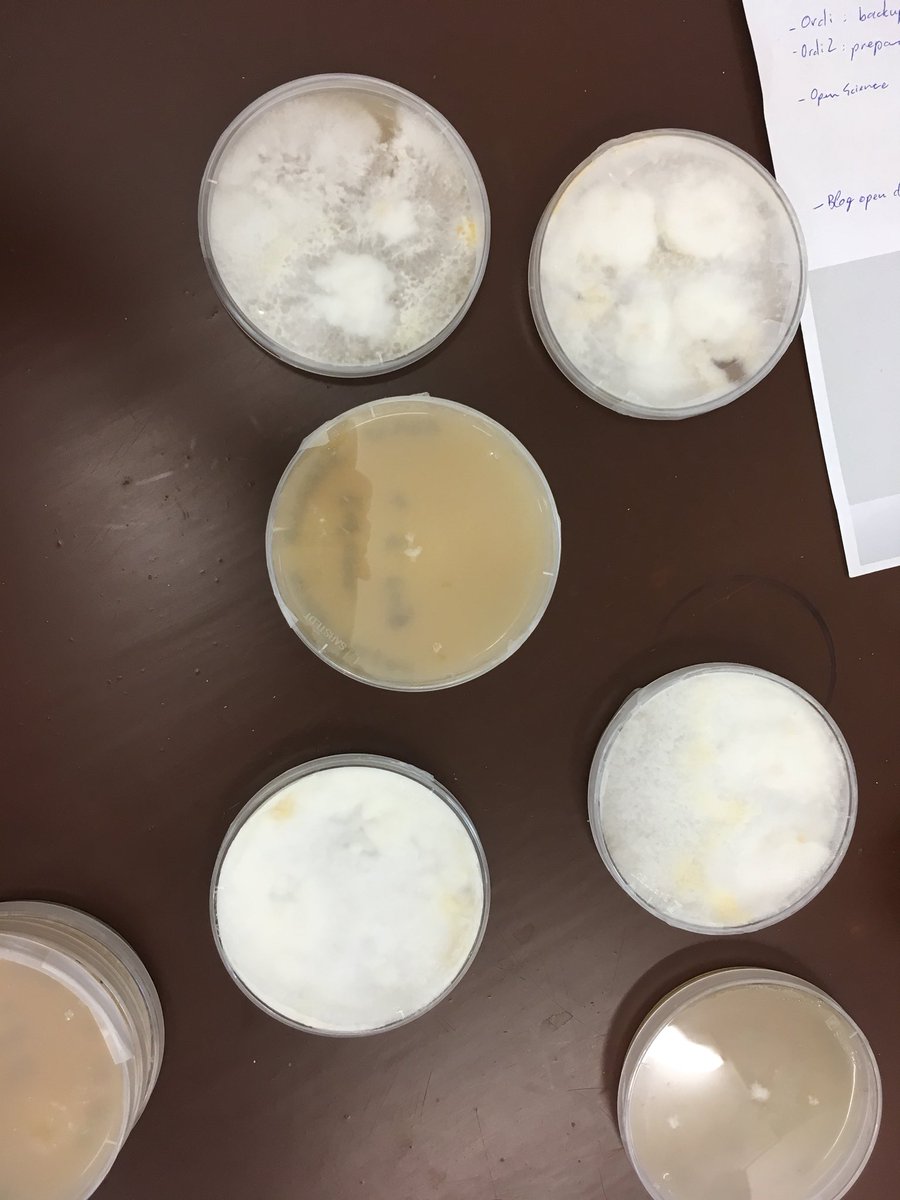
TOP Lab tweet media

Talk about the role of microcontrollers as platforms to design #OpenSource lab equipment @fossasia summit.
Date: Sunday 14.03 at 11 AM (CET) / 6 PM (SGT)
Link: eventyay.com/e/fa96ae2c/ses…




English
Alessandro Volpato
33 posts

@Volpato1985
Alessandro joins open-source biotech projects combining bio skills with hardware-software programming. He integrates bio-protocols on modular-drawn devices.












Now you can support Trend while shopping! via @AmazonSmile, Amazon will make a donation to Trend In Africa. use this link: smile.amazon.co.uk/ch/1186066-0